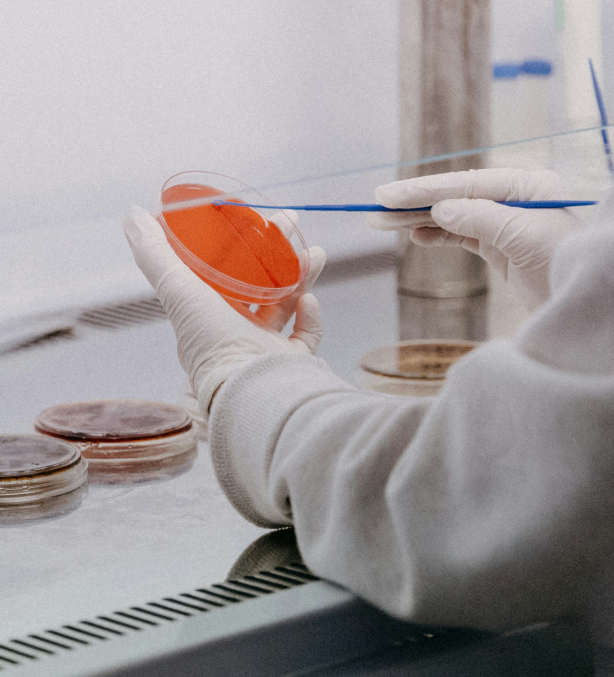
tech

미래 의료지표의 중심
Global Top Tier SCL HealthcareGlobal Top Tier SCL Healthcare
Scroll Down
Mission
우리의 미션은 품질, 서비스,
연구로 인류의 건강과
행복한 미래에 기여하는
것입니다.우리의 미션은 품질, 서비스, 연구로
인류의 건강과 행복한 미래에
기여하는 것입니다.우리의 미션은 품질, 서비스, 연구로
인류의 건강과 행복한 미래에 기여하는 것입니다.
Key Personnel
국내 바이오 헬스케어
분야 핵심 연구진이
SCL헬스케어를
이끌어가고 있습니다.국내 바이오 헬스케어 분야 핵심 연구진이
SCL헬스케어를 이끌어가고 있습니다.
Services and R&D
혁신적인 서비스와 연구개발을 소개합니다